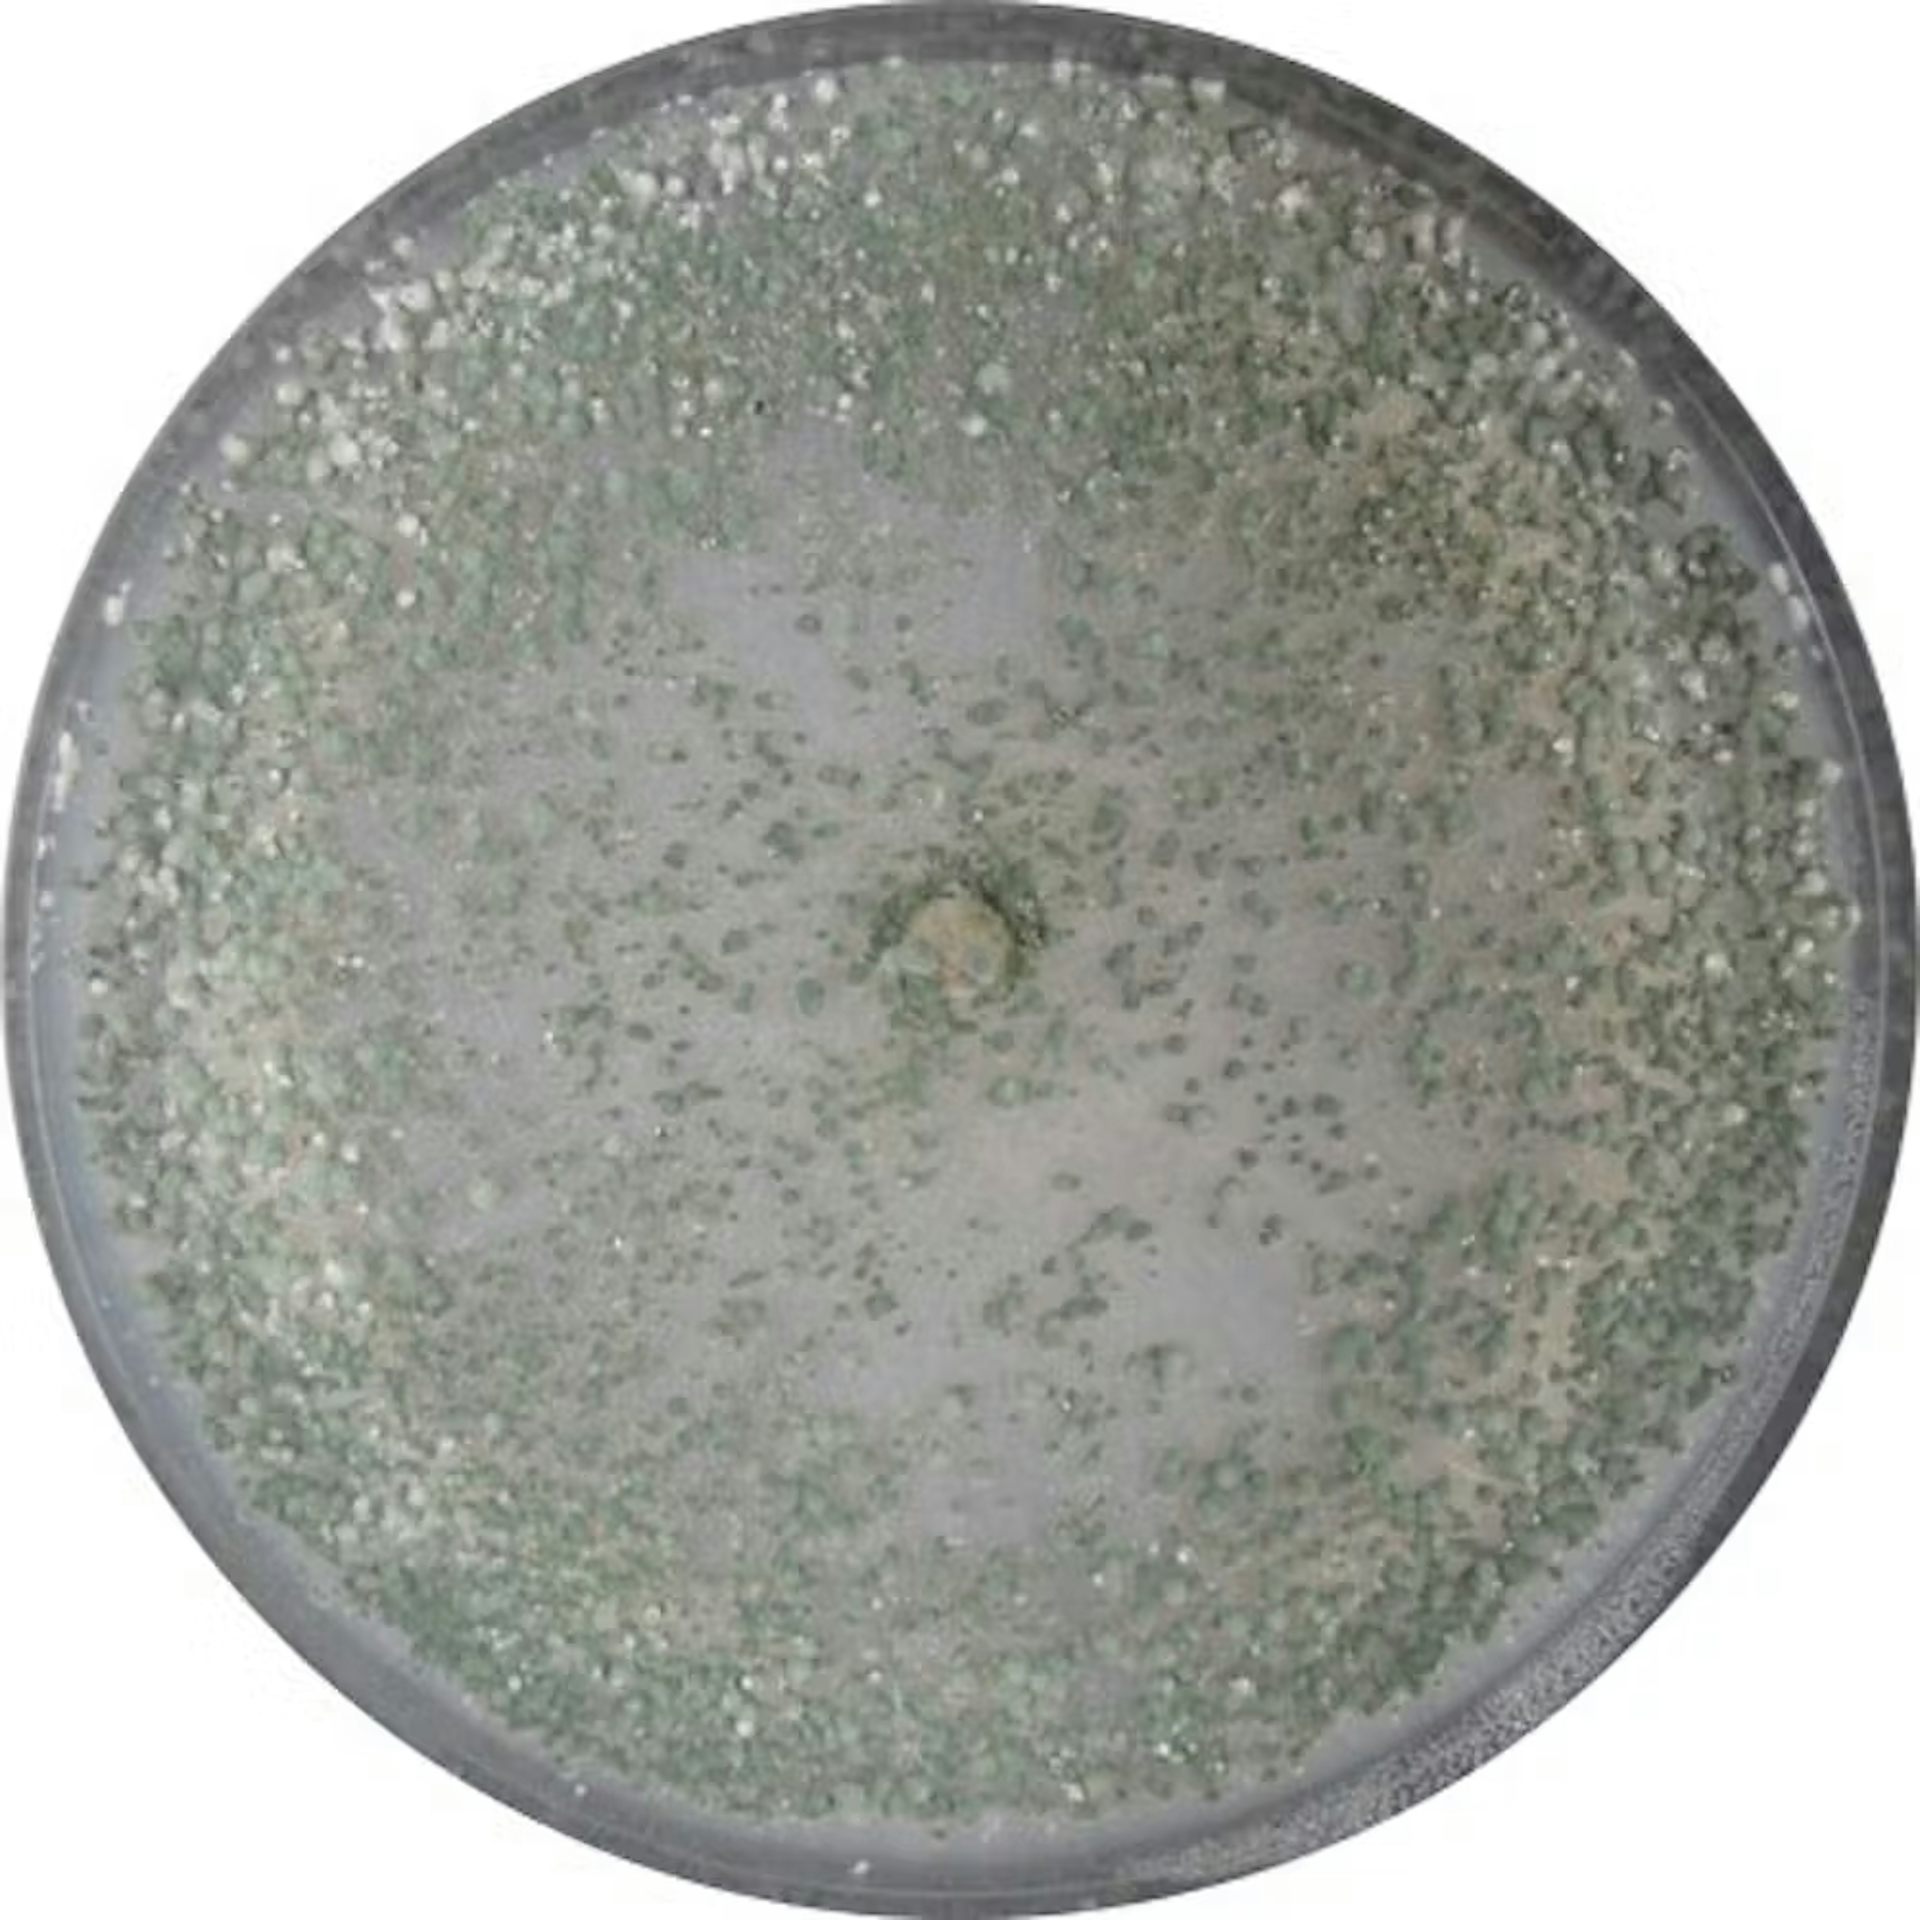
file 20260118 56 o2e4lf.jpg?ixlib=rb 4.1

Cuando un patógeno nos “ataca”, nuestro sistema inmunológico entra en acción y nos protege de las enfermedades “matando” a ese invasor dañino. Aunque de forma completamente diferente, las plantas también tienen su propio sistema inmunológico, que las protege de diversas infecciones.
Cuando un patógeno ingresa al cuerpo humano, entran en juego dos tipos de células: macrófagos y células dendríticas (o de Langerhans). La forma en que funcionan estas células de defensa es fagocitar directamente al intruso, digerirlo y matarlo, o fagocitar células que han sido atacadas por el patógeno, eliminándolas de la misma forma. Tanto los macrófagos como las células dendríticas actúan contra cualquier invasor que entre en el organismo -sin saber primero “quién” está atacando- a través de la llamada respuesta inmune innata.
Cuando un patógeno es digerido, estas células de defensa toman pequeñas moléculas (llamadas antígenos) y las colocan en el exterior. Después de eso, se acercan a otras células de defensa, llamadas linfocitos T, y les “enseñan” estos antígenos. De esta forma, los linfocitos T aprenden a reconocer el patógeno y, cuando vuelva a atacar, lo destruirán de forma más rápida y eficaz.
Un macrófago que ha engullido un hongo patógeno. Wikimedia Commons, CC BI Señales hormonales defensivas
En el caso de las plantas, su sistema inmunológico funciona de forma muy diferente, porque no tienen células de defensa moviéndose por sus órganos. Funciona a través de señales hormonales y respuestas de defensa. Cuando un patógeno ataca a una planta -por ejemplo, una hoja- la planta reconoce el patógeno a través de sus células y desarrolla dos tipos de respuestas.
Por un lado, una respuesta local, en la hoja atacada, donde se sintetizan compuestos antimicrobianos u otras moléculas que “matan” al invasor. Por otro lado, la respuesta de defensa se activa en toda la planta (o sistémicamente): envía hormonas (como el ácido salicílico y el ácido jasmónico) que activan respuestas de defensa en otros órganos de la planta, como otras hojas o raíces.
Estas señales hormonales provocan la acumulación en estos otros órganos de la planta de las mismas moléculas de defensa que actuaron sobre la primera hoja infectada, preparando a toda la planta frente a un posible futuro ataque de patógenos.
“Vacunas” a base de hierbas
Sin embargo, no siempre es necesario un ataque de patógenos para que la planta active sus defensas. Cuando microorganismos beneficiosos, como bacterias u hongos, entran en contacto con las raíces, la planta activa estas mismas respuestas de defensa en sus hojas. Por tanto, estos microorganismos actúan como “vacunas” que preparan a las plantas para defenderse mejor de posibles patógenos que puedan infectarlas.
Uno de estos microorganismos benéficos es el hongo Trichoderma, el cual es muy utilizado como biofungicida en agricultura para combatir otros hongos patógenos que atacan a los cultivos.
Además de colonizar las raíces e inducir las defensas de las plantas, Trichoderma actúa mediante otras estrategias antifúngicas. Por ejemplo, produce compuestos químicos tóxicos para los hongos patógenos. Pero también es capaz de atacarlos directamente, atraparlos y digerirlos desde dentro hasta morir.
Trichoderma hamatum. Jorge Poveda. Experimenta con brócoli
Por otro lado, dentro del grupo de los hongos dañinos encontramos una gran variedad de microorganismos muy diferentes, como por ejemplo Sclerotinia sclerotiorum. Este patógeno ataca las raíces, tallos, hojas y frutos de diversos cultivos, provocando lesiones negras que crecen hasta provocar la pudrición completa de la planta, la cual queda cubierta de moho blanco.
Uno de los grupos de cultivos que puede ser atacado por Sclerotinia sclerotiorum son las brassicas, entre las que se incluyen las hortalizas (brócoli, repollo, col, coliflor, etc.), las cuales son muy consumidas por sus propiedades nutricionales (antioxidantes, anticancerígenas, etc.).

Podredumbre blanca causada por Sclerotinia sclerotiorum en frutos de tomate. Wikimedia Commons., CC BI
Utilizando el brócoli como cultivo, Sclerotinia sclerotiorum como patógeno y Trichoderma hamatum como hongo beneficioso, investigadores de la Universidad de Valladolid y la Misión Biológica de Galicia (CSIC) descubrieron un nuevo mecanismo de inmunidad en plantas muy similar al ya conocido en humanos.
Sistema inmunológico similar al humano
Nuestra pregunta inicial fue: ¿Trichoderma puede actuar como macrófagos o células dendríticas? La respuesta es sí. En el suelo cerca de las raíces, un espacio llamado rizosfera entra en contacto con tricodermas y hongos patógenos. En nuestro estudio realizamos este contacto hongo-hongo con Trichoderma hamatum y Sclerotinia sclerotiorum.

Brócoli. Wikimedia Commons, CC BI
Después de detectar el hongo patógeno, Trichoderma produce enzimas digestivas llamadas quitinasas y glucanasas. Rompen la pared celular del patógeno y liberan moléculas llamadas oligómeros, compuestas de quitina y glucano. Cuando las raíces reconocen estos oligómeros activan sus defensas en toda la planta. Como consecuencia, cuando el patógeno ataca las hojas, no puede infectarlas.
Por tanto, Trichoderma actuaría como un macrófago o una célula dendrítica humana, pero para las plantas. Liberaría antígenos (en forma de oligómeros) de la pared celular del patógeno (Sclerotinia), poniéndolos a disposición de la raíz de la planta, para que pueda activar sus defensas y defenderse del patógeno cuando ataque.
Este estudio nos enseña que las plantas pueden desarrollar mecanismos de inmunidad sorprendentemente similares a los de los animales, gracias a las interacciones con microorganismos beneficiosos del suelo. Aprendimos que hongos como Trichoderma no sólo actúan como agentes de control biológico directo, sino que también desempeñan un papel clave como “mediadores inmunológicos”, ayudando a la planta a reconocer sus patógenos de antemano y activar defensas sistémicas efectivas.
Esta novedad amplía nuestro conocimiento sobre la complejidad del sistema inmunológico de las plantas y abre interesantes aplicaciones en agricultura sostenible, como el diseño de estrategias de protección de cultivos basadas en microorganismos beneficiosos que actúan de forma similar a la vacunación. Esto reduciría el uso de productos químicos y mejoraría la salud y la productividad de las plantas.
Descubre más desde USA TODAY NEWS INDEPENDENT PRESS US
Suscríbete y recibe las últimas entradas en tu correo electrónico.


